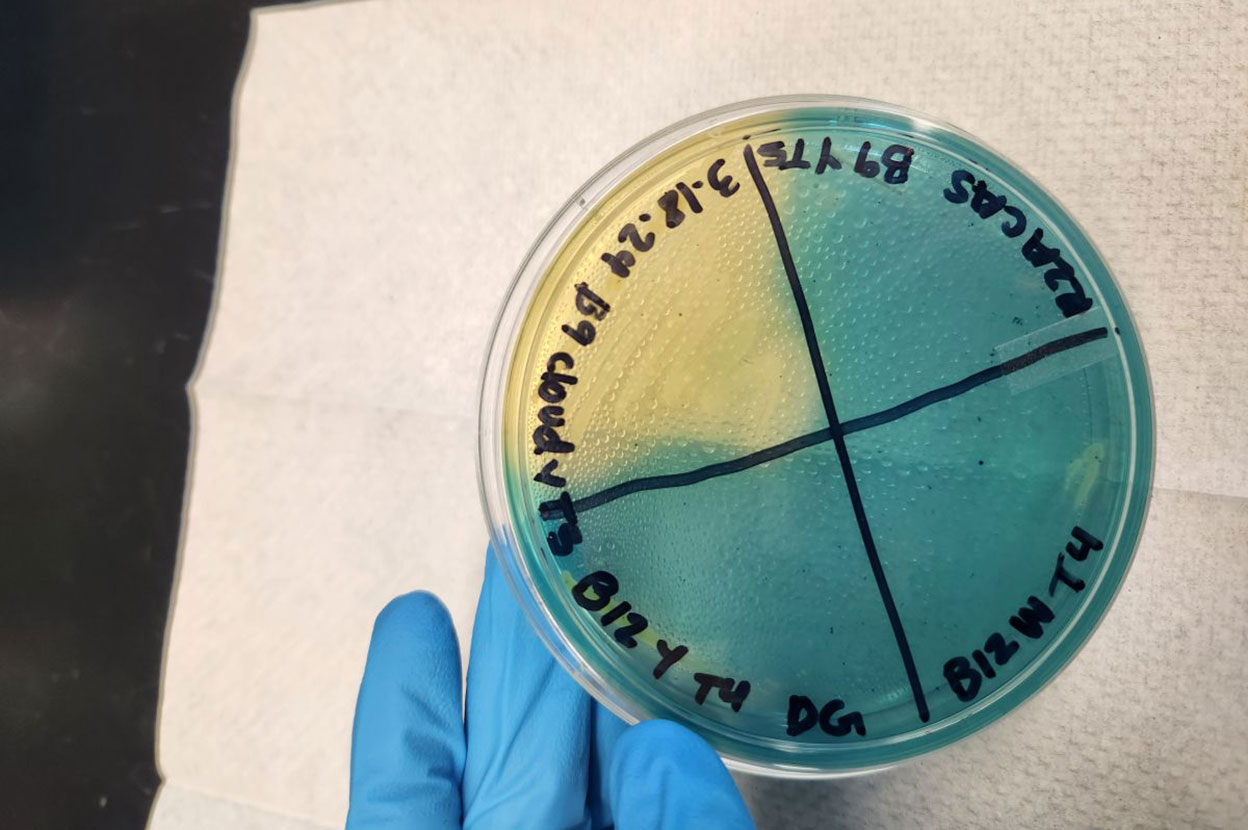
A CAS assay test with yellow section indicating microbes binding to rare-earth elements

small
PHONE
PHONE
lsmall
Large PHONE
Large PHONE
medium
TABLET
TABLET
large
DESKTOP
DESKTOP
xlarge
HD
HD
xxlarge
2k
2k
xxxlarge
4k
4k